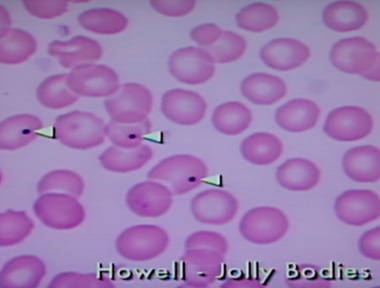

Describe the manner in which iodide is taken into thyroid follicular cells as well as the role of thyroid peroxidase. Additionally, in what disease are antibodies against thyroid peroxidase (anti-TPO antibodies) generated?
An 80-year-old man, who continues to smoke despite his COPD, has had a productive cough for almost 4 months. He even had to be hospitalized during the past December for respiratory infection that severely compromised his ability to oxygenate. In which pulmonary disease would you see an increased Reid index?
Chronic bronchitis
Reid index = gland depth/total thickness of bronchial wall - >50%
What is the mechanism of action and clinical use for varenicline?
Which branchial arch has derivatives that begin with “S”? What are these derivatives?
When an infant is born and takes its first breath, the lungs expand creating negative pressure that draws blood into the pulmonary circulation. Because the pressure in the pulmonary circulation is lower than that in the aorta, blood preferentially flows into the pulmonary circulation and the ductus arteriosus closes. What other fetal blood vessels are closed in the adult circulation?
A 55-year-old woman is diagnosed with estrogen receptor-positive breast cancer. What class of drugs would be used to treat her? What is another use for these drugs? What is the main concern when using tamoxifen?
Psoriasis is characterized by an increase in the stratum spinosum and a decrease in the stratum granulosum. What are the layers of the epidermis beginning with the most superficial layer? What is Auspitz sign?
“Californians Like Girls In String Bikinis”
Bleeding spots when scales are scraped off - clinical feature of psoriasis

A 15-year-old girl is brought to the pediatric ER. She is in some distress and has the following symptoms: rapid, deep breathing; vomiting; abdominal pain; and dry mucous membranes. Finger stick glucose is >500 mg/dL. What other lab abnormalities do you expect to find?
A 3-year-old patient who presented with splenomegaly and jaundice undergoes a splenectomy after being diagnosed with hereditary spherocytosis.
“Even Some Killers Have Pretty Nice Capsules”
Howell-Jolly bodies - basophilic nuclear remnants found in RBCs
A 35-year-old patient is on highly active antiretroviral therapy (HAART) including zidovudine, didanosine and ritonavir. A routine CBC to monitor the HAART reveals a megaloblastic anemia. Which medication is the most likely cause of the ill effect? What is the mechanism of action of zidovudine and didanosine? What is the mechanism of action of ritonavir?
A 22-year-old man lost his leg last week in a tragic accident involving alcohol and heavy machinery. He is medically able to be discharged home tomorrow, and the paperwork is already set up so he can leave in the morning. However, the nurse pulls you aside and informs you that the patient has been very depressed about his lost limb, and she overheard him talking to a friend about just ending his life with his dad’s gun when he gets out of the hospital. What must be done?
What neurotransmitter levels in the brain are either increased or decreased in the following diseases?
· Schizophrenia
· Parkinson disease
· Alzheimer disease
· Huntington disease
What organisms are particularly known for causing infective endocarditis?
A 23-year-old man is a victim of a motor vehicle collision. He suffered a traumatic brain injury and is in a coma. The attending surgeon tells the intern on ICU call to monitor the patient for the Cushing reaction. What is the Cushing reaction?
In your own words, describe what type II (β) error is.
Stating there is no effect or difference, when one does exist
What is Bias?
How can bias be reduced?
What arteries supply the adrenal glands? From what arteries do these arteries arise?

An adult trauma patient begins to experience shortness of breath on day 3 of his hospital stay. The patient had an open reduction internal fixation of a right femur fracture. You are concerned the patient’s shortness of breath might be attributed to an embolus. The patient is certainly at risk for an embolus because of prolonged immobility. Why else might the patient be at risk for an embolus? What are the different types of emboli?
How is cystic fibrosis diagnosed?
Sweat chloride test is gold standard -> >60 mEq/L on 2 or more occasions, this makes the diagnosis; Genetic testing for CFTR gene mutation identifies 90% of CF cases (used if unequivocal sweat chloride or confirm and determine prognosis based on specific mutation); Nasal transepithelial chloride secretion.
What medications are used in the treatment of the pulmonary component of cystic fibrosis? │BAD HANI β2 Agonists (albuterol short acting or long acting - salmeterol, formoterol); DNase I (dornase alfa) ↓ viscosity sputum by breaking down long strands of DNA in sputum of CF patients; Hypertonic saline (given with nebulizer to help hydrate mucous); Azithromycin (Routine to slow decline of lung function); N-acetylcysteine (nebulized, breaks up mucus, not used as often anymore); Ibuprofen to help reduce inflammation
“BAD HANI”
A 35-year-old man is having a partial colectomy for diverticular disease. The patient is placed on neomycin prior to the bowel surgery. What class of medication is neomycin? What is the mechanism of action of neomycin? What are the toxicities with this class of medication?
On your neurology rotation, a 27-year-old woman comes in for a check-up and renewal of her prescription for β interferon therapy. What is the classic triad of symptoms in multiple sclerosis? With what disorders do patients with multiple sclerosis commonly present?
Autoimmune inflammatory disease causing demyelination of Brain and Spinal cord, most often women in 20s and 30s, whites
A 31-year-old patient of yours complains of chronic back stiffness and pain. X-ray reveals a spine that looks similar to bamboo. What other symptoms may be present with this disease, and into what category of diseases does this one fall?
“Bamboo spine” = Ankylosing Spondylitis - 40% Inflammation of eye - Uveitis, Iritis causing redness, eye pain and vision loss, floaters, photophobia;
